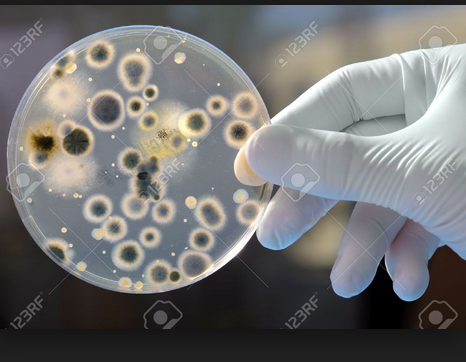

Information string flowcharts by Herb Zinser reviews LANGUAGE word clues about subset math and science word clues in books, newspapers, magazines, etc.
List of pages and topics … covered later with the numbered, handwritten pages
Page
2 President Kennedy and Tamir Rice mirror
3 President hydrogen and nitrogen codes
4 KLM quantum levels
5 Elements of Style
8 atomic mass –> AMerican codes
9 Goethe order entry
10 Nikola Tesla alternating cycles
11 poetry data entry
12 John Keats poetry year 1818
13 18 atomic columns in year 1818
14 18 water molecule mass in year 1818
15 set theory ERRORS of Massachusetts
16 Scotland … James Clerk Maxwell and Andrew Carnegie
17 Tesla EARTH vibrations and echo signatures
18 John Keats walking proteins
19 EARTH geology and earth data pipelines ..wormholes …input and output code
21 iambic pentameter
22 JOHN Keats walking VS Boston running
23 poetry stanza …z-axis codes and Stanton Heights poetry …. shooting police
24 Lord Byron …. carbon atom poetry messages
25 AB poetry blood type AB
26 Percy Bysshe Shelley ….. VS Shelby, North Carolina communication problems
27 harness racing tracks and IBM 3380 tracks
28 ISAM delete people with Son of ISAM
29 Edgewater Technology shooting December 26, 2000
30 Burger King and Perry Mason
31 Grand 16 theater shooting
32 Seattle and the Orfice of OR = Oregon
33 Carl Jung
34 Peter Kessing age 26 killed
35 Sikh Temple
36 blood software
37 Jeffrey Fowle age 56
38 Kathryn Stalbaum
39 Fermat’s Last theorem
40 Magna Carter
42 Magna Cum Laude
43 Brad Pitt forensic secrets of Pittsburg
44 eye cones/rods software wars
45 Father Brown TV and uranium 92 protons
46 Fez Morocco math class
47 Timbuktu and TIME MACHINES
48 Time Horton and its Time restaurants
49 John Dalton wars ….. .Alton Sterling
50 Dylann Roof math class
51 Norris Hall protein chains
52 Cole Hall and the grateful dead
53 Osiris and the BOOK of the DEAD
54 World Trade Center year 1993 bombing
55 brain levels of thought
56 Basement levels of the 1993 bombing
57 Bethesda Luther Home and Pabst Farms
58 brain Septum attacks on Sept 11,2001
The evolution of the living language with math and physics equations, computer science flowcharts, biochemistry diagrams. etc has resulted in a new version of LANGUAGE …… known by various terms as
the Universal Mind Language,
Nature’s SYMBOL MACHINE language,
Carl Jung collective unconsciousness GROUP MIND expression systems of behavior and feeling that sometimes rises up to a surface level of information display ( crimes, protests, demonstrations, etc) and other language / behavior mechanics.
Books and printed news articles may contain subset messages that are embedded within the larger context of the written text.
read between the lines – Collins Dictionaries
www.collinsdictionary.com › English Dictionary
Example Sentences Including ‘read between the lines’.
Nothing was spelled out, yet everything was there for those who could read between the lines. Ashford …
In this blog post …… we shall provide information strings using WORDS and subset WORDS and see their relationship to REALITY events.
Nature’s SYMBOL MACHINE is comprised of nouns, verbs, concepts, math equations, flowcharts, etc. The ideas found in BASIC math and science college textbooks are part of the SYMBOL MACHINE.
Using Galileo’s suggestions of ” 2 CHIEF WORLD SYSTEMS” we now perceive Sartre existentialism as partitioned into 2 or more data spaces……. the 2 CHIEF existential entities
1) physical reality of objects: concrete highways, iron automobiles, cellulose trees, humanoids, atoms, molecules, gravity fields, EARTH iron core, etc.
2) The world of symbols, concepts, process control system flowcharts, biochemistry diagrams, math and physics equations, etc.
Maps and Territories – Rijnlandmodel
Language in Thought and Action, S.I. Hayakawa.
Chapter 2 Symbols Maps and Territories
There is a sense in which we all live in two worlds.
For example ………… Charles Dickens ” TALE of 2 Cities” ….. about two worlds on the EARTH surface.
What is the 2nd world?
Thus we have the source domain of SYMBOL LIFE and THOUGHT that may get a
mathematical-physics mapping to the destination range of physical biology with human proper nouns, human activities, etc on the geography surface of EARTH …….
that is…… the EARTH surface as an information display surface using 3-dimensional vertical humans and their behavior and daily activities.
data for those in science.
Thus … in this blog post you have some information strings ….. the language fabric and its LINKS to physical reality and events.
Black Holes & Time Warps | W. W. Norton & Company
books.wwnorton.com › Science › Astronomy
W. W. Norton & Company
Black holes, down which anything can fall but from which nothing can return; … Kip Thorne, along with fellow theorists Stephen Hawking and Roger Penrose, … tapestry of interlocking themes, coming finally to a uniquely informed answer to the …
tapestry of interlocking themes, coming finally to a uniquely informed answer to the …
tapestry of interlocking themes, coming finally to a uniquely informed answer to the …
tapestry of interlocking themes, coming finally to a uniquely informed answer to the …
Information string ……. BLOG POST
John F. Kennedy – Wikipedia 
John Fitzgerald “Jack” Kennedy (May 29, 1917 – November 22, 1963), commonly referred to by his initials JFK, was an American politician who served as the 35th President of the United States from January 1961 until his assassination in November 1963. The Cuban Missile Crisis, the Bay of Pigs Invasion, the Nuclear Test Ban Treaty, the establishment of the Peace Corps, developments in the Space Race, the building of the Berlin Wall, the Trade Expansion Act to lower tariffs, and the Civil Rights Movement all took place during his presidency. Kennedy was a member of the Democratic Party, and his New Frontier domestic program was largely enacted as a memorial to him after his death. Kennedy also established the Presidential Medal of Freedom in 1963.
Shooting of Tamir Rice – Wikipedia
The shooting of Tamir Rice, a carbon 12 ….. 12-year-old African-American boy (June 25, 2002 – November 23, 2014), occurred on November 22, 2014, in Cleveland, Ohio.
Enemy | Define Enemy at Dictionary.com 
Enemy | Definition of Enemy by Merriam-Webster 
Define enemy: someone who hates another : someone who attacks or tries to harm another — enemy in a sentence.
Enemy
En em
…….. em
Nemesis | Nemesis Definition by Merriam-Webster 
nemesis Meaning in the Cambridge English Dictionary 
nemesis meaning, definition, what is nemesis: Someone’s nemesis is a person or thing that is very difficult for them to defeat.. Learn more.
Faust – Wikipedia 
https://en.wikipedia.org/wiki/Faust
Faust is the protagonist of a classic German legend. He is a scholar who is highly successful yet dissatisfied with his life, which leads him to make a pact with the Devil, exchanging his soul for unlimited knowledge and worldly pleasures. The Faust legend has been the basis for many literary, artistic, cinematic, and musical works that have reinterpreted it through the ages. “Faust” and the adjective “Faustian” imply a situation in which an ambitious person surrenders moral integrity in order to achieve power and success for a delimited term.[1][2]
The Faust of early books—as well as the ballads, dramas, movies, and puppet-plays which grew out of them—is irrevocably damned because he prefers human to divine knowledge; “he laid the Holy Scriptures behind the door and under the bench, refused to be called doctor of Theology, but preferred to be styled doctor of Medicine“.[1] Plays and comic puppet theatre loosely based on this legend were popular throughout Germany in the 16th century, often reducing Faust and Mephistopheles to figures of vulgar fun
The EARTH ground/soil as a data entry surface ……
the above …2-legs act like 2-fingers on a computer keyboard
Nikola Tesla’s Earthquake Machine – The Excluded Middle 
In the last years of the 19th century, technological alchemist Nikola Tesla may … A vibration sent through the earth returns an “echo signature” using the same …
vibration sent through the earth returns an “echo signature”
vibration sent through the earth returns an “echo signature”
vibration sent through the earth returns an “echo signature”
On Wisconsin: Landmark church gets $1.2 million makeover in … 
Nov 20, 2011 – The addition of 12-by-7-inch copper shingles to the St. Bernard’s Catholic Church’s spire has made this Watertown … revealing the finished work by Langer Roofing of Milwaukee and Hunzinger Construction of Brookfield.
John Keats (/ˈkiːts/; 31 October 1795 – 23 February 1821) was an English Romantic poet. He was one of the main figures of the second generation of Romantic poets, along with Lord Byron and Percy Bysshe Shelley, despite his work’s having been in publication for only four years before his death.[1]
Although his poems were not generally well received by critics during his lifetime, his reputation grew after his death, and by the end of the 19th century, he had become one of the most beloved of all English poets. He had a significant influence on a diverse range of poets and writers. Jorge Luis Borges stated that his first encounter with Keats’s work was the most significant literary experience of his life.[2]
The poetry of Keats is characterised by sensual imagery, most notably in the series of odes. This is typical of romantic poets, as they aimed to accentuate extreme emotion through the emphasis of natural imagery. Today his poems and letters are some of the most popular and most analysed in English literature.
The poetry of Keats is characterised by sensual imagery, most notably in the series of odes.
The poetry of Keats is characterised by sensual imagery, most notably in the series of odes.
The poetry… in the series of odes.
The poetry… in the series of odes.
The poetry… in the series of codes ..computer science.
The p o etry… in the series of codes.
The podiatry order entry .. in the series of codes.
The poetry… in the series of odes.
The poetry… in the series of odes.
The poetry… in the series of codes ..computer science.
The p o etry… in the series of codes.
The podiatry order entry .. in the series of codes.
In June 1818, Keats began a walking tour of Scotland, Ireland, and the Lake District with his friend Charles Armitage Brown. Keats’ brother George and his wife Georgina accompanied them as far as Lancaster and then continued to Liverpool, from where the couple emigrated to America.
In June 1818,
In June 1818,
In June 1818,
In June 18 18 –> existence of 18 atomic columns and 18 water molecule
In June 1818, Keats began a walking tour of Scotland, Ireland, and the Lake District with his friend Charles Armitage Brown. Keats’ brother George and his wife Georgina accompanied them as far as Lancaster and then continued to Liverpool, from where the couple emigrated to America.
In June 1818,
In June 1818,
In June 18 = water100 and 18 = watertown
In June 1818,
In June 1818,
In Juneau Wisconsin nearby ….
code 18 (Watertown molecules) and 18 miles LINK
In June 1818, Keats began a walking tour
In June 1818, Keats influence …. data stream of consciousness .. began a walking tour
In June 1818, Keats began a walking tour of the Doge County fair by Juneau Wisconsin
,
18 teens cited for disorderly conduct after Dodge County Fair fight 
Eighteen Teens Cited For Dodge County Fair Fight – KFIZ.com 
Aug 22, 2013 – The Dodge County Sheriff’s Office has issued 18 citations for disorderly … Mayville, Burnett and Juneau and were from 13 to 17 years of age.
The poetry… in the series of odes.
The poetry… in the series of odes.
The poetry… in the series of codes .. B100D software bio-computer science.
The p o etry… in the series of codes.
The podiatry order entry .. in the series of codes of B100D
…..Water100 , Wisconsin secrets
………….. 100
…………B100D software languages …… words, nouns, thoughts
The Dodge County Sheriff’s Office has issued 18 citations …
feedback signal regrading ……. June year 1818
.
Keats’ brother George and his wife Georgina accompanied them as far
Keats’ brother George and his wife Georgina accompanied them as far
Keats’ brother George and his wife Georgina accompanied them as far
Keats’ brother George and his wife Georgina –> in other words
Blinded experiment – Wikipedia 
A blind — or blinded — experiment is an experiment in which information about the test is … If both tester and subject are blinded, the trial is called a double–blind experiment. Blind testing is used …. A good clinical protocol will foresee these potential problems to ensure blinding is as effective as possible. It has also been …
Double Blind Experiment – Avoiding Bias – Explorable.com 
A double blind experiment is an experimental method used to ensure impartiality, and avoid errors arising from bias.
Dzhokhar Tsa rna ev – Wikipedia 
Dzhokhar Anzorovich “Jahar” Tsarnaev is an American citizen born in Kyrgyzstan who was convicted of planting bombs at the Boston Marathon on April 15, …
In June 1818, Keats began a walking tour of Scotland,
In June 1818, Keats began a walking tour of Scotland,
tour of Scotland,
tour of Scotland,
tour of Scotland,
tour of Scotland, …………..
Andrew Carnegie – Wikipedia 
Andrew Carnegie was a Scottish American industrialist who led the expansion of the American steel industry in the late 19th century, and is often identified as …
Carnegie was born in Dunfermline, Scotland, and emigrated in 1848 to the United States with his parents. Carnegie started work as a telegrapher and by the 1860s had investments in railroads, railroad sleeping cars, bridges and oil derricks. He accumulated further wealth as a bond salesman raising money for American enterprise in Europe. He built Pittsburgh’s Carnegie Steel Company, which he sold to J.P. Morgan in 1901 for $480 million.[5]
Andrew Carnegie was born in Dunfermline, Scotland, in a typical weaver’s cottage with only one main room, consisting of half the ground floor which was shared with the neighboring weaver’s family.[7]
Dunfermline,
Dunfermline,
Dun fer m line,
Dun ferrous oxide IRON ….. magnetic field flow line,
Nikola Tesla’s Earthquake Machine – The Excluded Middle
In the last years of the 19th century, technological alchemist Nikola Tesla may … A vibration sent through the earth returns an “echo signature” using the same …
A vibration sent through the earth returns an “echo signature” using the same .
A vibration sent through the earth returns an “echo signature” using the same .
A vibration sent through the earth returns an “echo signature” using the same .
A vibration sent through the earth returns an “echo signature” using the same .
A vibration sent through the earth returns an “echo signature”
using the same Mantle word.
In June 1818, Keats began a walking tour of Scotland,
In June 1818, Keats began a walking tour of Scotland,
In June 1818, Keats began a walking tour of Scotland,
In June 1818, Keats began a walking tour of Scotland, —> Maxwell and Carnegie
Thus the data pipeline/ Einstein-Rosen communication bridge ……
the underground railroad (electron railroad or data tracks)
Below, left side year 1818 ..
John Keats data entry into the EARTH via the pressure of his body ..
say 160 pounds of weight (thus a data hole into the soi/ground ….. data wormhole….)
…… thus data input in year 1818 ..into COMPUTER EARTH’s intellect …that then ….
surfaces …year later VIA the Scotland agents …. Carnegie and then Maxwell
Underground Railroad – Wikipedia 
The Underground Railroad was a network of secret routes and safe houses established in the United States during the early-to-mid 19th century, and used by African-American slaves to escape into free states and Canada with the aid of abolitionists and allies who were sympathetic to their cause.
What is a Wormhole LINK
to the EARTH electronics ….. underground railroad? – Space.com 
Apr 13, 2015 – These paths, called Einstein–Rosen bridges or wormholes, connect two different points in space-time, theoretically creating a shortcut that could …
The Einstein-Rosen Bridge – Initiative for earthly Studies 
Jan 11, 2015 – Einstein and Rosen were investigating the possibility of an atomistic … connected by a bridge or a Schwarzschild wormhole with a ‘throat’.
Underground Railroad – Black History – HISTORY.com 
Harriet Tubman and the Underground Railroad. Born a slave, Harriett Tubman became a famous “conductor” on the Underground Railroad, leading hundreds of slaves to freedom. … The most famous “conductor,” an escaped slave named Harriet Tubman, reportedly made nineteen return trips …
In June 1818, Keats began a walking tour of Scotland
In June 1818, Keats began a walking tour of Scotland
In June 1818, Keat’s
INTERNAL amino acid chains began an
EXTERNAL chain of steps …..message steps ,,, walking tour of Scotland
The Saturday Review of Politics, Literature, Science and Art 
HERBERT SPENCER’S PRINCIPLES OF PSYCHOLOGY!t original book on Psychology—that is to …. He first treats of bodily Life, efin ,lt to .e “ correspondence of internal with external relations ;” an in rill”s yet mastcrl … 352 The [March 1, 1856.
In June 1818, Keats began a walking tour of Scotland
In June 1818, Keats began a walking tour of Scotland
Underground Railroad and Jules Verne earthly electron/ gravity field communication Wormholes- Wikipedia 
Physics – Focus: The Birth of information Wormholes and
the Andrew Carnegie weaver cottage / string theory … empirical data FOUNDATION clues
Mar 25, 2005 – A 1935 idea from Albert Einstein and Nathan Rosen for unifying … This construction makes a smooth connection or bridge between two distinct …
In June 1818, Keats began a walking tour of Scotland, Ireland, and the Lake District with his friend Charles Armitage Brown.
the Lake Michigan District of Chicago with his
friend 2244 west Charleston Street, Armitage Street, and Brownstone brick/stone buildings
Keats & Iambic Pentameter « PoemShape 
Ode to a Nightingale Form and Meter – Shmoop 
Keats and his Romantic peers almost single-handedly revived the ode form for modern readers with … Iambic pentameter is the most common meter in English.
Iambic pentameter – Wikipedia 
https://en.wikipedia.org/wiki/Iambic_pentameter
Iambic pentameter /aɪˈæmbɪk pɛnˈtæmᵻtər/ is a commonly used type of metrical line in traditional English poetry and verse drama. The term describes the rhythm that the words establish in that line, which is measured in small groups of syllables called “feet“. The word “iambic” refers to the type of foot that is used, known as the iamb, which in English is an unstressed syllable followed by a stressed syllable. The word “pentameter” indicates that a line has five of these “feet”.
Iambic pentameter is the most common meter in English poetry; it is used in many of the major English poetic forms, including blank verse, the heroic couplet, and some of the traditional rhymed stanza forms. William Shakespeare used iambic pentameter in his plays and sonnets.
Metre
Sample example
An iambic foot is an unstressed syllable followed by a stressed syllable. The rhythm can be written as:
da DUM
The da-DUM of a human heartbeat is the most common example of this rhythm.
A standard line of iambic pentameter is five iambic feet in a row:
da DUM da DUM da DUM da DUM da DUM
Straightforward examples of this rhythm can be heard in the opening line of William Shakespeare‘s Sonnet 12:
- When I do count the clock that tells the time
and in John Keats‘ To Autumn:[1]
- To swell the gourd, and plump the hazel shells
The 2013 Boston Marathon took place in Boston, Massachusetts on Monday April 15, 2013. It was the 117th edition of the mass-participation marathon. Organized by the Boston Athletic Association, it was the second of the World Marathon Majors series to be held in 2013. Over 23,000 runners participated.
Over 23,000 runners participated.
Over 23,000 runners participated.
Over 23,000 runners participated in the attack on EARTH languages ….
.
Boston Marathon Event Information – Boston Athletic Association 
DISTANCE: 26 MILES,
Lord Byron – Wikipedia 
George Gordon Byron, 6th Baron Byron, FRS (22 January 1788 – 19 April 1824), commonly known simply as Lord Byron, was a British poet, peer, politician, and …
She Walks in Beauty
Poem
Analysis of She Walks in Beauty by Lord Byron | Minhyung’s Blog 
Aug 3, 2011 – The first stanza of the poem describes the physical appearance of the woman. Byron starts the poem with the phrase “She walks in beauty, like
Adam Lanza – the poetry wars ,,,,, stanza Murder instructions
– Biography.com 
Sandy Hook Elementary School poetry message ….
shooting – Wikipedia 
2009 shooting of Pittsburgh
po –> poetry
po –> police officers – Wikipedia 
On April 4, 2009, a shootout occurred at 1016 Fairfield Street in the Stanton Heights neighborhood of Pittsburgh, Pennsylvania, United States, stemming from a mother and her 22-year-old son’s argument over a dog urinating in the house. At approximately 7:11 a.m. EDT, 22-year-old Richard Poplawski opened fire …
She Walks in Beauty
Poem
L. Byron: She Walks in Beauty – Google Sites 
Apr 19, 2013 – Main Poem: She walks in beauty … SHE walks in beauty, like the night … It is divied into 3 stanzas, each 6 lines long, with a ABABAB style …
It is divided into 3 stanzas, each 6 lines long,
It is divided into 3 stanzas, each 6 lines long,
It is divided into 3 stanzas ….. neutron, proton, electron
,,,,,,,,,,,,, each 6 lines long, …………
Lord Byron ….. blood software package ……
: She Walks in Beauty – Google Sites 
Apr 19, 2013 – Main Poem: She walks in beauty … SHE walks in beauty, like the night … It is divied into 3 stanzas, each 6 lines long, with a ABABAB style …
with a ABABAB style …
with a ABABAB style …
with a AB AB AB style …
Why Is AB Blood Type So Rare? It’s All About The Red Blood Cells 
Mar 25, 2016 – “Blood group A has only A antigens.” Similarly, blood group B has only B antigens, blood group AB has both, and blood group O has neither A nor B antigens on the surface of the red blood cells. These four groups are the most important because they indicate which blood type a patient can safely receive in a transfusion.
AB Positive Blood Type Facts
about Lord Byron arteries OUTPUT messages|
Thrombocytes 
AB Positive Blood Type Facts (AB+). 1. Universal Plasma Donor and Universal Red Cell Recipient. The nature of antigens present in the serum determines the …
Blood type – Wikipedia 
A blood type is a classification of blood based on the presence and absence of antibodies and …. Therefore, an individual with type AB blood can receive blood from any group (with AB being preferable), but cannot donate blood to any group …
Heme | definition of heme by Medical dictionary 
Heme binds and carries oxygen in the red blood cells, releasing it to tissues. Also spelled haeme. See also hemoglobin, porphobilinogen, protoporphyrin.
Heme | definition of heme
Heme | definition of heme OUTPUT formats
Heme | definition of Theme …. SCheme
Percy Bysshe Shelley – Wikipedia 
https://en.wikipedia.org/wiki/Percy_Bysshe_Shelley
Percy Bysshe Shelley ( i/ˈpɜːrsi ˈbɪʃ ˈʃɛli/;[2] 4 August 1792 – 8 July 1822) was one of the major English Romantic poets, and is regarded by some as among the finest lyric, as well as most influential, poets in the English language. A radical in his poetry as well as in his political and social views, Shelley did not see fame during his lifetime, but recognition for his poetry grew steadily following his death. Shelley was a key member of a close circle of visionary poets and writers that included Lord Byron, Leigh Hunt, Thomas Love Peacock, and his own second wife, Mary Shelley, the author of Frankenstein.
i/ˈpɜːrsi ˈbɪʃ ˈʃɛli/;[2] 4 August 1792 – 8 July 1822) was one of the major English Romantic poets, and is regarded by some as among the finest lyric, as well as most influential, poets in the English language. A radical in his poetry as well as in his political and social views, Shelley did not see fame during his lifetime, but recognition for his poetry grew steadily following his death. Shelley was a key member of a close circle of visionary poets and writers that included Lord Byron, Leigh Hunt, Thomas Love Peacock, and his own second wife, Mary Shelley, the author of Frankenstein.
Shelley is perhaps best known for such classic poems as Ozymandias, Ode to the West Wind, To a Skylark, Music, When Soft Voices Die, The Cloud and The Masque of Anarchy. His other major works include a groundbreaking verse drama The Cenci (1819) and long, visionary poems such as Queen Mab (later reworked as The Daemon of the World), Alastor, The Revolt of Islam, Adonaïs, Prometheus Unbound (1820)—widely considered to be his masterpiece—Hellas: A Lyrical Drama (1821), and his final, unfinished work, The Triumph of Life (1822).
Shelley’s close circle of friends included some of the most important progressive thinkers of the day, including his father-in-law, the philosopher William Godwin and Leigh Hunt
Emanuel African Methodist Episcopal Church
Charleston church shooting – Wikipedia 
https://en.wikipedia.org/wiki/Charleston_church_shooting
The Charleston church shooting (also known as the Charleston church massacre[6][7][8]) was a mass shooting, hate crime, and act of terrorism that took place at the Emanuel African Methodist Episcopal Church in downtown Charleston, South Carolina, United States, on the evening of June 17, 2015. During a prayer service, nine people (including the senior pastor, state senator Clementa C. Pinckney) were killed by gunman Dylann Roof, a 21-year-old white supremacist. Three other victims survived. The morning after the attack, police arrested Roof in Shelby, North Carolina.
,
Percy Bysshe Shelley
Percy Bysshe Shelley
Percy By………Shell
Percy Byte…….Shell VS
Shelby North Carolina
incomplete explanations
Criminal investigation …..
includes the rigged omission of Alan Turing ….
SYMBOL MACHINE and CONCEPT MACHINE data about
Nature’s data generating systems and
Nature’s process of creation of tragic signaling EVENTS
Principle Quantum level …..
atomic bio-physics human expression organization
Department of Energy
…… cover-ups of some KLM quantum crashes
…… data signals about atomic social science ERRORS
Department of Energy and the FCC cover-up of the
Richard P. Feynman electromagnetic coupling wars …
played out ……….. VIA
Shell byte (Shelby)
relationship to Em Fields (EManuel church)
The Mysterious 137 – Richard Feynman 
The Feynman Lectures on Physics Vol. I Ch. 2: Basic Physics 
Of course, if we watch long enough, we may eventually catch on to a few of the rules. ….. The electromagnetic field can carry waves; some of these waves are light, ….. the strength of the interaction is measured by some number, which is 1 / 137 . The detailed law of this coupling is known, that is quantum electrodynamics.
on the morning after the attack,
Roof was captured in a traffic stop in Shelby, North Carolina,
Dylann Roof
……
rigged information choreography .
omission of evidence and living English language DATA,
– Wikipedia
Jump to Trial and sentencing – At the jail, his cell-block neighbor was Michael Slager, the former North Charleston officer charged with first-degree murder in the wake of his shooting of Walter Scott. Dylann Roof is the first person in U.S. history to have faced both a state and federal death penalty at the same time.
Jan 10, 2017 – Dylann S. Roof was found guilty of 33 counts in connection with the … sentencing decision effectively capped Mr. Roof’s federal trial for the …
Harness racing – Wikipedia 
Harness racing is a form of horse racing in which the horses race at a specific gait (a trot or a pace). They usually pull a two-wheeled cart called a sulky, although in Europe racing under saddle (trot monté in French) is also conducted
What Is the Difference Between a Trotter & a Pacer? | Animals – mom.me 
The horizontal/ latitude TRACKS
for COMPUTER EARTH data
Diameter Growth. Each year, Nature’s expression …. the COMPUTER tree forms new cells, arranged in concentric circles called annual rings or annual growth rings. These annual rings show the amount of wood produced during one growing season. In Canada and the North United States, the growing season begins in the spring.
Annual growth rings | Tree knowledge | Booklet | Forest Academy … 
IBM Archives: IBM 3380 direct access storage device 
IBM Archives: IBM 3380 direct access storage device – page 3 
Sports News, Scores, Schedules, Standings, Stats, Photos, Videos …
MSN Sports provides latest sports news, scores, standings, stats, photos & videos.
ISAM – Wikipedia 
What is ISAM (Indexed Sequential Access Method)? – Definition from … 
Indexed Sequential Access Method (ISAM)- IBM 
ISAM refers to two access methods: basic indexed sequential access method (BISAM) and queued indexed sequential access method (QISAM). Data sets …
Bio-computer SON of I,Sam
ISAM-style implementations
- Advantage Database Server database manager
- Berkeley DB –> the Berkowitz implementation
ISAM
ISAM
area. If you subsequently add a new record; ISAM stores it in an overflow area and maintains
links to point to it. (ELB: In what follows, the reader should recall that a disk cylinder can
be defined functionally as a set of records that the read/write heads can access without being
physically moved. Track–to–track head motion is time consuming, taking about 10 msec.)
with a blank when you create the file. You also code OPTCD=L in the DCB macro or the
DD command. When you want to delete a record, store X’FF’ in this byte. QISAM
subsequently will not be able to retrieve the record. QISAM automatically drops the
record when the file is reorganized. Let’s examine some features of OS ISAM processing.
Database Management 
David Berkowitz – Murderer – Biography.com 
Wakefield massacre at Edgewater Techology …..
MUSIC WAR site – Wikipedia 
The Wakefield massacre occurred on Tuesday, December 26, 2000, at Edgewater Technology in Wakefield, Massachusetts, United States, during which the gunman, Michael “AotC” McDermott, an application support employee, shot and killed …
Wakefield massacre – Wikipedia 
https://en.wikipedia.org/wiki/Wakefield_massacre
The Wakefield massacre occurred on Tuesday, December 26, 2000, at Edgewater Technology in Wakefield, Massachusetts,
December 26, 2000, at Edgewater
December 26 ..runway 26 message from Lexicon Kentucky
December 26, 2000, at Edgewater
December 26, 2000, at Edgewater
December 26, 2000, at Edge water
……
runway 26 repeated …… people run 26 mile race in Boston and
,,,then Watertown message
$100 Burger King Gift Card Sweepstakes – PrizeGrab 
Enter to win $100.00 Burger King Gift Card! You’re allowed only 2 Entries per day, so make sure you enter EVERY DAY quick and easy! No purchase necessary.
$100 Burger
Hamilton Burger – Wikipedia 
Hamilton Burger is the fictional Los Angeles County District Attorney (D.A.) in the long-running series of novels, films, and radio and television programs …
Perry Mason (TV series) – Wikipedia 
Hamilton Burger codes
HamBurger …. secret languages
$100 Burger King Gift Card
Digestive Disorders & Gastrointestinal Diseases | Cleveland Clinic 
Functional disorders are those in which the gastrointestinal (GI) tract looks normal but doesn’t work properly. They are the most common problems affecting the GI tract (including the colon and rectum). Constipation and irritable bowel syndrome (IBS) are two common examples.
Digestive Disorders & Gastrointestinal Diseases
Digestive Discussion orders per HCL agent Hillary CL
Role of Hydrochloric Acid in the Stomach | LIVESTRONG.COM 
Apr 11, 2011 – Hydrochloric acid, also called HCl, is a clear, highly corrosive liquid. HCl is one of the many chemicals released in our stomach when we eat a …
Hillary Clinton’s tenure as Secretary of State – Wikipedia 
Hillary Clinton served as the 67th United States Secretary of State, under President Barack Obama, from 2009 to 2013, overseeing the department that …
Hillary Clinton’s tenure as Secretary of State – Wikipedia 
Hillary Clinton’s tenure as Secretary of State
HCl tenure as Secret of ate … food for thought mystery
Century 16 …. 2012 Aurora shooting – Wikipedia 
On July 20, 2012, a mass shooting occurred inside a Century 16 movie theater in Aurora, Colorado, during a midnight screening of the film The Dark Knight …
Base 16 HEX ordered massacre at
Virginia Tech leaves 32 dead – Apr 16, 2007 –
HISTORY of computer science CAD…
Computer Aided Design of human bio-computer CAD.avers
On this day in History, Massacre at Virginia Tech leaves 32 dead on Apr 16, 2007. Learn more about what happened today on History.
Pentagon and Washington,DC cover-up of the Base 16 ….
2015 Chattanooga shootings – Wikipedia 
Muhammad Youssef Abdulazeez opened fire on two military installations in Chattanooga, Tennessee, on July 16, 2015. He first committed a drive-by shooting at a recruiting center, then traveled to … A Navy sailor, a Marine recruiter, and a police officer were wounded; the sailor died from his injuries two days later.
Orifice war in
Or = Orfices of
Or = Oregon people Wikipedia 
Orifice …… eat ….. Sit/seat …… seattle EAT with
Bill Gates and Nature’s systems theory
of human Mouth Gates in Seattle
| Define Orifice at Dictionary.com
an opening or aperture, as of a tube or pipe; a mouthlike opening or hole; mouth; vent. Origin of orifice Expand.
Appendix (Anatomy):
INTERNAL Appendix Picture, Location, Definition, Function … 
Feb 18, 2017 – WebMD’s Appendix Anatomy Page provides detailed images, definitions, and information about the appendix. Learn about its function, parts, …
Appendix (Anatomy):
INTERNAL Appendix Picture, Location, Definition, Function
Appendix (Anatomy):
Externalization of biology internal maps …. map location
Appendix (Anatomy):
EXTERNAL Appendix Picture, Location, Definition, Function
Fort Dix: US Army Support Activity 
ASA Fort Dix Training Requests must be submitted 30 days prior to the …. U.S. Army Reserve Command, at Joint Base McGuire-Dix-Lakehurst, New Jersey, July …
Fort Dix – Wikipedia 
Fort Dix, the common name for the Army Support Activity located at Joint Base … Army Support Activity Fort Dix is located in Burlington County, New Jersey.
ISIS Behead Peter Kassig on Video – YouTube 
SIS beheads another american hostage | protothemanews.com 
Nov 16, 2014 – ISIS beheads another american hostage … As international media broadcasts, it is American Peter Kassig, who had … Tags With: kessing.
Jihadi John Leads Systematic Beheading of Peter Kassig and 18 … 
Nov 17, 2014 – Up to 18 prisoners are beheaded in one of the most graphic scenes from an official IS video.
4 New ISIS video shows beheading of American hostage Peter Kassig 
Nov 16, 2014 – ISIS claims to have beheaded hostage Peter Kassig … than a dozen captured Syrian soldiers, but did not show the beheading of Peter Kassig, age 26.
Peter Kassig, age 26.
Iron-56 communication ERRORS and VIOLATIONs
of Nature’s periodic table …..
atomic mass …mass communication laws …..
by Illinois Route 56
– Wikipedia 
Iron-56 (56Fe) is the most common isotope of iron. About 91.754% of all iron is iron-56. Of all nuclides, iron-56 has the lowest mass per nucleon. With 8.8 MeV binding energy per nucleon, iron-56 is one of the most tightly bound nuclei.
Wisconsin Sikh temple shooting – Wikipedia 
On August 5, 2012, a massacre took place at the gurdwara (Sikh temple) in Oak Creek, Wisconsin, where 40-year-old Wade Michael Page fatally shot six people …
Gunman Kills 6 at Sikh Temple in Wisconsin – The New York Times 
Aug 5, 2012 – Family members waited for information outside the Sikh temple in Oak Creek, Wis., where a shooting took place on Sunday. Credit Mike De …
Sikh temple
Below, the airplane VIEW …of the earth surface of the University of Virginia
….. as an Nature’s earth printed circuit board
American says N. Korean detention over Bible worth it – USA Today 
Jeffrey Edward Fowle – Wikipedia 
Jeffrey Edward Fowle (born c. 1958) is an American citizen arrested in North Korea in May 2014 for leaving a Bible in a nightclub in the northern port city of Chongjin (CITY of IRON)
The “Tale of Two Cities of IRON’ with Charles Dickens
….. blood IRON Heme Fe(2) group software / the living languages
Town on edge after 15-year-old girl disappears
from the Waukesha area (CITY of IRON) 
Kathryn Stalbaum Missing: Teen Disappeared While Bicycling To … 
Nov 7, 2013 – Inspector Eric Severson of the Waukesha County Sheriff’s Department said Kathryn J. Stalbaum left her Genesee home at about 6:15 a.m. …
Missing teen found alive in Chicago 
Nov 8, 2013 – This photo of Genesee teen Kathryn Stalbaum was sent out by the Waukesha County Sheriff’s Department before she was found. Credit: …
Missing teen found alive in Chicago
Mis……………………dali vein….. Chicago Art Institute
…. blood arteries software/ picture languages and secret codes
Inventions of the Monsters | The Arteries Institute of Chicago 
Salvador Dalí | Inventions of the Monsters
(1937 and codes –> K atom 19 electrons and 37 degrees Celsius … human temperature of agent K atom –> Kat –> Kathryn Stalbaum )
| Artsy 
From Art Institute of Chicago, Salvador Dalí, Inventions of the Monsters (1937), Oil on canvas, 51.4 × 78.4 cm.
Kathryn Janeway | Memory Alpha | Fandom powered by Wikia 
Vice Admiral Janeway. … “There are three things to remember about being a starship captain: keep your shirt tucked in, go down with the ship, and never abandon a member of your crew.” … Kathryn Janeway was a 24th century Starfleet officer, most noted for her service as captain of the …
Scientific American: Earthly Parallel language Universes 
Apr 14, 2003 – The parallel universes of your alter egos constitute the Level I multiverse. It is the least controversial type. We all accept the existence of things .
The existence of alternate universes on EARTH – Slate 
Aug 20, 2003 – The next month, Scientific American published a long article by the physicist Max Tegmark asserting that, to the contrary, parallel universes almost certainly do … different versions of the same entities, like your own alter ego.
Kettle Moraine High School principle quantum atgent – Wikipedia 
https://en.wikipedia.org/wiki/Kettle_Moraine_High_School
Principal, Jeff Walters (2011-Present …… in other words
pre-sent …. atoms and THOUGHT molecules to the
present time to appear as EARTH LAB
proper noun: Jeff)
Kathryn Janeway | Memory Beta, non-canon Star Trek Wiki | Fandom … 
Kathryn M. Janeway was a Human female in Starfleet during the 24th century. In 2371, she assumed…
15 Year-old girl missing from genetics movie Town of Gene …..
Town of Genesee and Moraine … molecular conversations
– WISN.com
Kathryn Stalbaum disappeared Tuesday morning on her way to school.
Jeffrey Fowle, American Held by North Korea, Is Freed – The New York … 
Oct 21, 2014 – Jeffrey E. Fowle, who was held in North Korea for six months, apologized … Mr. Fowle, 56, an Ohio municipal worker, entered North Korea on a …
Mr. Jeffrey Fowle, age 56,
Mr. Jeffrey Fowle, age 56 message for Principal, Jeff Walters of Waukesha area
… Fe = Ferrous oxide iron thoughts
to Fe = Ferrous oxide iron agents
… Fermat and Feynman …………
Richard Feynman – Wikipedia 
Richard Phillips Feynman was an American theoretical physicist known for his work in the path ….. At Caltech, Feynman investigated the physics of the superfluidity of supercooled liquid helium, where helium seems to display a complete lack of …
The Fe yn man ………….. Lectures on bio-math, blood math, and Physics – Wikipedia 
The Feynman Lectures on Physics is a physics textbook based on some lectures by Richard P. Feynman, a Nobel laureate who has sometimes been called “The Great Explainer”. The lectures were presented before undergraduate students at the California Institute of Technology (Caltech),
…
Magna Carta – Wikipedia 
Magna Carta Libertatum commonly called Magna Carta is a charter agreed to by King John of England at Runnymede, near Windsor, on 15 June 1215.
Magna Carta – British History – HISTORY.com 
Magna Carta an introduction …..
Magna Carta an introduction …..
Magnetic field interaction with carbon life forms – The British Library 
Magna Carta – Wikipedia 
Magna Carta Libertatum commonly called Magna Carta is a charter agreed to by King John of England at Runnymede, near Windsor, on 15 June 1215.
Magna Carta – British History – HISTORY.com 
Mag na Car ta an introduction – The British Library 
Magna Carta, meaning ‘The Great Charter’, is one of the most famous documents in the world. … Most of the 63 clauses granted by King John dealt with specific grievances relating to his rule. … Most famously, the 39th clause gave all ‘free men’ the right to justice and a fair …
Magna Cum Laude – Wikipedia 
A rarely-used distinction, maxima cum laude, “with very great honor”, is an intermediary honor between the magna and the summa honors. It is sometimes used when the summa honor is reserved only for students with a perfect academic record.
Magna Cum Laude – Investopedia 
Magna cum laude is an academic level of distinction used by educational institutions to signify an academic degree that was received “with great honor.” Magna cum laude is one of three commonly used types of Latin honors that are recognized in the United States, the other two being summa cum laude and cum laude.
Magna Cum Laude
Criminal Forensic Studies – Pitt-Brad ….. Bradford – University of Pittsburgh 
A minor in criminal forensic studies is designed to provide students with a theoretical and applied understanding of the nature of criminal investigations and how ..
Criminal Forensic Studies Minor – Catalog – University of Pittsburgh 
Criminal Justice – BA – Pitt-Bradford – University of Pittsburgh 
Discover how to go beyond at the University of Pittsburgh at Bradford, a safe, … technologically advanced criminal forensic equipment in the country with our …
BBC One – Father Brown 
BBC One – Father Brown – Episode guide 
BBC One – Father Brown, Series 1 
Series 1. Father Brown. Drama based on the stories by GK Chesterton, about a crime-solving … On TV. There are no upcoming broadcasts of this programme .
BBC One
…..COne ….. programming the human eyeball cones/rods
with possible schemes
David B. Cline | UCLA Physics & Astronomy 
Prof.David Cline – UCLA Astronomy 
Cline
Travis Zoellick (20) ….. 20/00 vision interceptor agent killed in optical wars and … 
Woman gets 25-year sentence for role in killing – Jsonline 
UWM student was kidnapped, killed over car, authorities say – Jsonline 
Oct 7, 2008 – … Mitsubishi Lancer Evolution, and Travis W. Zoellick wanted one just … were searching for him, and he confessed to killing Khan over a car.
Father Brown (2013 TV series) – Wikipedia 
Father Brown is a British television period drama which began airing on BBC One on 14 January 2013. It features Mark Williams as the eponymous …
Father Brown
Missouri cop was badly beaten before shooting Michael Brown, says … 
Chief: Officer noticed Brown carrying suspected stolen cigars 
Aug 15, 2014 – Michael Brown was identified as a suspect in a strong-arm robbery of a box of … The report describes Brown as 6’4, 292 pounds and wearing a …
292 pounds and wearing a …
292 pounds and wearing a …
2 .. 92 pounds of secret codes
Shooting of Michael Brown – Wikipedia 
The shooting of Michael Brown occurred on August 9, 2014, in Ferguson, Missouri, a northern suburb of St. Louis. Brown, an 18-year-old black man, was fatally …
What Happened in
Fer = FermiLAB that caused
Fer = Ferguson? – The New York Times 
Aug 9, 2014 – Michael Brown, an unarmed black teenager, was shot and killed on Aug. 9, 2014, by Darren Wilson, a white police officer, in Ferguson, Mo., .
was shot and killed on Aug. 9, 2014, by Darren Wilson,was shot and killed on Aug. 9, 2014, by Darren Wilson,was shot and killed on Aug. 9, 2……. by D arr en Wilson,was shot and killed on Aug 92 ……. by Data array energy
Wilson HALL (errors) of the Federal government …. atomic social scince nonsense
was shot and killed on Aug 92
was shot and killed on Aug 92
was shot and killed on Aug 92
–> Nature’s periodic atomic table … uranium 92 proton prose … the
DNA codon announcement of the START WAR codon AUG
Nature’s integrity and accuracy ……
LANGUAGE and LINGUISTICS quality control systems
VERSUS citizen dribble talk and Washington DC approval of bull-story explanations of tragic signaling events
Episode Three | Episode Guide | Africa’s Great Civilizations – PBS 
… in present-day Morocco, a walled city within the city, host Henry Louis Gates, … Gates visits the Almohad city of Fez, a major network of exchange founded in .
Gates visits the Almohad city of Fez,
Gates visits the Almohad city of Fez,
Gates visits the Almohad city of Fez ….math and bio-math city
complex math entire Functions(ez) –> F(ez)
Fez —> ez
The Road to Timbuktu – PBS 
Watch Full Episodes Online of Africa’s Great Civilizations on PBS 
In his six-hour series, AFRICA’S GREAT CIVILIZATIONS, Henry Louis Gates, … Video thumbnail: Africa’s Great Civilizations City of Timbuktu | Africa’s Great …
The Road to Timbuktu
Warren Buffett – Wikipedia 
Warren Edward Buffett is an American business magnate, investor, and philanthropist. He is considered by some to be one of the most successful investors in …
Warren Buffett
Here’s Why Warren Buffett Is Investing $3 Billion in the Burger King … 
Why data Buffer King –> Burger King is Now Warren Buffett’s Favorite Franchise … 
Feb 29, 2016 – The octogenarian billionaire Warren Buffett is often photographed enjoying a Dairy Queen Blizzard at a local Omaha DQ. At the Berkshire …
Warren Buffett opens up about why Burger King bought Tim Hortons … 
Exclusive: Burger King and Tim Hortons owner nears deal to buy … 
Feb 21, 2017 – Exclusive: Burger King and Tim Hortons owner nears deal to buy … 3G Capital’s long-time partner, Warren Buffett’s Berkshire Hathaway Inc, ..
Buffett opens up about why Burger King bought Tim Hortons .
Field Effect Transistor (representative) Buffer Time Hour
Tim Hortons 
Welcome to Tim Hortons. Our Always Fresh Coffee, hot beverages, cold beverages and many quick meal options will hit the spot any time of day.
Tim Hortons Nutrition Information | Find a Tims Menu Item 
Sandwiches and Hot Bowls | Tim Hortons 
Hot Bowls. Comfort food at its best, our Mac & Cheese and hearty Homestyle Chili are deliciously satisfying and sure to warm your heart. Learn More …
Tim Hortons
Boston Marathon Event Information – Boston Athletic Association 
Boston Marathon Mile 27 – Official Post-Race Party presented by Samuel Adams · Volunteer … DISTANCE: 26 MILES,
Relay race – Wikipedia 
During a relay race, members of a team take turns running, orienteering, swimming, cross-country skiing, biathlon, or ice skating (usually with a baton in the fist) parts of a circuit or performing a certain action. Relay races take the form of professional races and amateur games.
Baton – definition of baton by The Free Dictionary 
relay race | race format | Britannica.com 
baton | relay race | Britannica.com 
The relays involve four runners per team, each member carrying a baton for 25 percent of the total distance before passing it to the next team runner. Two events …
baton | relay race
The attack on the John Dalton DATABASE
results in the Shooting of Alton Sterling – Wikipedia 
On July 5, 2016, Alton Sterling, a 37-year-old black man, was shot several times at close range while held down on the ground by two white Baton Rouge Police …
Alton Sterling Shooting in Baton Rouge Prompts
cover-up explanation by the myopic Justice Department specialists
in the Alan Sokal and CP Snow “SCIENCE WARS ”
. 
Jul 6, 2016 – Alton Sterling, a 37-year-old black man, was shot and killed by officers of the Baton Rouge Police Department on Tuesday. The shooting was ..
New hearing date set for John Dalton agent ……
Jason Dalton statements in atomic mass … mass shooting … 
Catching Uber gunman ‘good police work and a little bit of luck’ | MLive … 
Feb 19, 2017 – Jason Dalton is accused of crisscrossing Kalamazoo County in a shooting rampage.
2009 STANDARD MODEL battle in Pittsburgh – Wikipedia 
On April 4, 2009, a shootout occurred at 1016 Fairfield Street in the Stanton Heights neighborhood of Pittsburgh, Pennsylvania, United States, stemming from a …
Dylann Roof – Wikipedia 
Dylann Storm Roof (born April 3, 1994) is an American mass murderer and white supremacist convicted of perpetrating the June 17, 2015, Charleston church …
Dylann Roof
Dylann Roof ..math agent
math calculus functions and the derivative /slope
math calculus functions and the derivative /slope of church DEMO
Grandfather Apologizes After Dylann Roof’s Guilty Pleas Add to … 
1 day ago – Dylann S. Roof in court at the Charleston County Judicial Center on Monday to enter his guilty plea on murder charges. Credit Pool photo by …
Dylann Roof: Charleston Church Roof /slope
… calculus derivative …Shooter
Gets DNA nucleotide GuaNINE
…..Nine Life Sentences in … 
1 day ago – — Convicted Charleston church shooter Dylann Roof was given nine consecutive life sentences in state prison after he pleaded guilty to state murder charges Monday, leaving him to await execution in a federal prison and sparing his victims and their families the burden of a
Timeline: How the Virginia Tech shootings unfolded | World news … 
Aug 30, 2007 – 9.15-9.30am: Cho is seen outside and then inside Norris Hall, an engineering building. He chains the doors shut on the three main entrances …
inside Norris Hall
inside Norris Hall
inside Norris Hall
inside N = Nitrogen H = Hydrogen
He chains the doors shut on the three main entrances …
He chains the doors shut on the three main entrances …
He chains the doors shut on the three main entrances …
The Cars ……. a group of singing carbohydrate molecules
– Wikipedia
Grateful Dead Live at Evans Field House – Northern Illinois University … 
Grateful Dead Live at Field House, Northern Illinois U on 1977-10-29 … 
Grateful Dead Live at Evans Field House, Northern Illinois University … 
Mar 21, 2008 – Venue Evans Field House, Northern Illinois University Location Dekalb, Il Source MSR>PCM>DAT>CDx?>EAC>WAV>FLAC Transferred by …
Grateful Dead Live at Einstein’s Field THEORY House, Northern Illinois
NFL legend Junior Seau found murdered at his Oceanside, California home 
May 2, 2012 – Former NFL linebacker Junior Seau was found dead Wednesday morning at his Southern California home. He was 43 years old.
1984 – Why is Oceania only at war with Oceanside, California? – Science … 
May 11, 2014 – Oceania, however is always at war with only one. … 1984 george-orwell …. The 2 times we are told which side is which, Oceania, Winston’s .
Osiris – Ancient History Encyclopedia 
Osiris, ruler of the Underworld 
Osiris, first king of Egypt, is murdered by his brother Seth. His body becomes the first mummy. Sovereign of the Hereafter, every dead is prosecuted before his …
Osiris, ruler of the Underworld
Egyptian Book of the Dead – Ancient History Encyclopedia 
Book of the Dead – Wikipedia 
The Book of the Dead is an ancient Egyptian funerary text, used from the beginning of the New ….. In many occasions, the deceased is mentioned as “The Osiris – [Name]” in the Book of the Dead. Two ‘gate spells’. On the top register, Ani and his …
Columbine High School massacre – Wikipedia 
https://en.wikipedia.org/wiki/Columbine_High_School_massacre
The Columbine High School massacre was a school shooting that occurred on April 20, 1999, at Columbine High School in Columbine,[3][4] an unincorporated area of Jefferson County in the American state of Colorado. In addition to the shootings, the complex and highly planned attack involved a fire bomb to divert firefighters, propane tanks converted to bombs placed in the cafeteria, 99 explosive devices, and carbombs. The perpetrators, senior students Eric Harris and Dylan Klebold, murdered 12 students and one teacher. They injured 21 additional people, and three more were injured while attempting to escape the school. The pair subsequently committed suicide.[5][6]
11:29 a.m. – 11:36 a.m.: Library massacre
Although their precise motives remain very clear …..
I’m OK – You’re OK by Thomas A. Harris MD | Influenced by Eric Berne 
Description of Transactional Analysis and Games by Dr. Eric Berne MD 
Transactional Analysis, created by Eric Berne, defines three different ego states in … Or, as Berne’s student Thomas A. Harris said “I not only remember how I felt, …
1993 World Trade Center bombing – Wikipedia 
1993 World Trade Center Bombing Fast Facts – CNN.com 
Remembering the 1993 World Trade Center Bombing – History in the … 
Feb 26, 2013 – On February 26, 1993, terrorists parked a rental van in a garage underneath the World Trade Center’s twin towers and lit the fuses on a …
On Friday, February 26, 1993
1993 + 20 amino years
On the Boston race of 26 miles 2013
… feedback message about 20 standard acid years
Boston Marathon 26 mile message … bomb – Wikipedia 
On April 15, 2013, two homemade bombs detonated 12 seconds and 210 yards (190 m) apart at 2:49 p.m., near the finish line of the annual Boston Marathon, …
An unprecedented manhunt for Dzhokhar Tsarnaev ensued on April 19,
with thousands of law enforcement officers searching
a 20-block area of Watertown
to year 1993 and number 26 of February 26
Lutheran Home for Feeble Minded and Epileptics – Asylum Projects 
Bethesda Lutheran Home – Watertown Historical Society 
Bethesda Lutheran Communities. Founded 1903. 1903. 07 14 A home for feeble–minded and epileptic children will be built in Watertown during the ensuing …
Lutheran Home for Feeble Minded
Lu = Logical Unit …
Lu = Lutheran Home for
Fe = Ferrous oxide IRON software ….
Fe = Feeble Minded agents protected from the modern bull-shit song and dance by Nature’s INTELLECTUAL systems
History – Pabst Farms – Experience A Rare Way Of Life 
UW Press: Pabst Farms: The History of a Model Farm 
Wisconsin-centric books include history of Pabst Farms, tales of … 
Dec 26, 2014 – Credit: From ‘Pabst Farms: The History of a Model Farm’ … Pabst Farms was first known for breeding Percheron and Hackney horses, but as automobiles ascended, Pabst’s operation concentrated on Holstein cattle. John C.
Septum pellucidum – Wikipedia 
The septum pellucidum (translucent hedge) is a thin, triangular, vertical double membrane separating the anterior horns of the left and right lateral ventricles of …
Know your brain: Septum — Neuroscientifically Challenged 
Dec 8, 2016 – The term septum, when used in reference to the brain (it is a common anatomical term used to refer to a partition), indicates a subcortical …
Know your brain: Septum
Know your brain: Septum
Know your brain: Septum ordered attack for September 11, 2001
The Two Cultures – Wikipedia, the free encyclopedia
The Two Cultures is the title of the first part of an influential 1959 Rede Lecture by British scientist and novelist C. P. Snow. Its thesis was that “the intellectual life of the whole of western society” was split into the titular two cultures — namely the sciences and the humanities — and that this was a major hindrance to solving the world’s problems. …
Snow’s position can be summed up by an often-repeated part of the essay:
A good many times I have been present at gatherings of people who, by the standards of the traditional culture, are thought highly educated and who have with considerable gusto been expressing their incredulity at the illiteracy of scientists. Once or twice I have been provoked and have asked the company how many of them could describe the Second Law of Thermodynamics. The response was cold: it was also negative. Yet I was asking something which is the scientific equivalent of: Have you read a work of Shakespeare’s?[5]
I now believe that if I had asked an even simpler question — such as, What do you mean by mass, or acceleration, which is the scientific equivalent of saying, Can you read? — not more than one in ten of the highly educated would have felt that I was speaking the same language. So the great edifice of modern physics goes up, and the majority of the cleverest people in the western world have about as much insight into it as their neolithic ancestors would have had.[5]
















































































































































































































































































































































































































































































































































































































































































































































































































































































































































































 or A = A T ¯ {displaystyle A={overline {A^{text{T}}}}}
or A = A T ¯ {displaystyle A={overline {A^{text{T}}}}}  , in matrix form.
, in matrix form. is denoted by A H {displaystyle A^{H}}
is denoted by A H {displaystyle A^{H}}  , then the Hermitian property can be written concisely as
, then the Hermitian property can be written concisely as